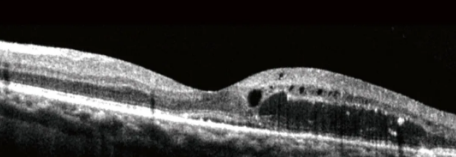

糖尿病是最常见的代谢性疾病。据国际糖尿病联盟(IDF)统计,截至2019年,中国是20~79岁糖尿病患者最多的国家,大约有1.164亿糖尿病患者。糖尿病并发症可累及多脏器。比如,眼、脑、心、神经和足等。
而每3例糖尿病患者就有1例糖尿病视网膜病变患者。糖尿病患者的高血糖状态可导致眼底视网膜微血管发生病变。若不加以重视,可以致盲。

1.“糖网”可致盲,早期筛查是关键
近年来,随着人们生活水平的提高和饮食结构的改变,糖尿病的发病率大大增加,我国糖尿病患病人数更是居世界第一。
糖尿病病人在患病一定时期后,会出现视网膜新生血管的形成以及出血,这是糖尿病最常见而又严重的眼部并发症——糖尿病视网膜病变。
糖尿病视网膜病变是一种眼底疾病,表现为视力减退、视野缩小等症状。视网膜病变发展到最后,将出现视网膜脱离、新生血管性青光眼等问题,最终导致失明。
在我国,患糖尿病30年以上发生视网膜病变的概率为95%。糖尿病视网膜病变已上升到致盲眼病的第四位。
糖尿病视网膜病变眼底OCT影像图
DR 可见浆液性网脱+囊样网脱,出现液性空腔
DR 视网膜隆起增厚,层间可见积液
DR 视网膜隆起增厚,层间可见积液与渗出;RPE连续性破坏
DR 视网膜层间水肿
2.“糖网”有何症状?
糖友一旦感到视力减退、夜间视力下降明显、近视程度加重,眼前有黑色悬浮物、看东西出现重影、双眼视野缩窄、视物有闪光感、视物变形,一定要及早就医,检查眼底。
糖尿病引起视网膜病变后,其病程发展是不可逆的,一旦视力明显下降便很难恢复,治疗难度也会增加,早发现、早诊断十分重要。
3.怎么预防和治疗“糖网”?
糖友本身要控制好自身的三高(血糖、血压、血脂)等指标,遵医嘱服药,培养清淡饮食、适量运动、戒烟等健康的生活方式,定期测量糖化血红蛋白(HbA1c<7%)。
无论有无视力改变,为了防止糖尿病眼底病变严重化,最大限度的保护视力,2型糖尿病一旦确诊,每年要做一次眼底检查,并规范治疗。
1型糖尿病,如果是在青春期前发病,12岁开始得进行每年一次眼底检查。一旦出现眼部任何不适,一定要及时就医,以免错过较佳治疗时机。
当视网膜血管病变严重、出现血管增生、黄斑水肿时,常需要联合激光、抗新生血管等治疗;出现视网膜脱离等晚期眼底病变,需要手术治疗。